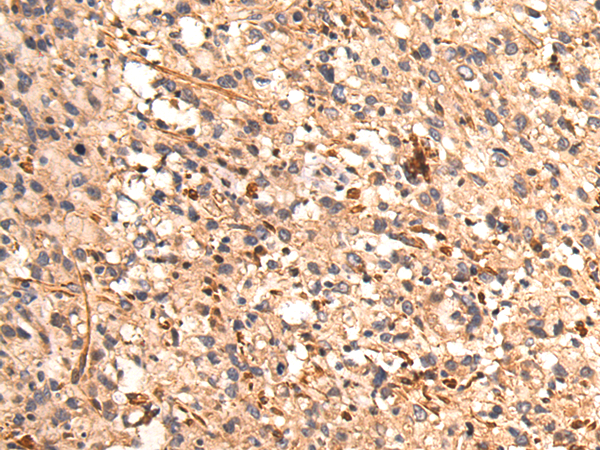
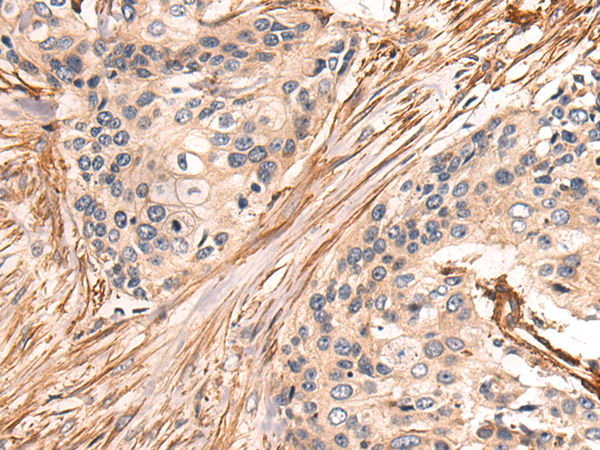

-
分类: 科研抗体货号: P10272别名: HT036应用: WB,IHC反应种属: Human, Mouse
-
分类: 科研抗体货号: P10271别名: RCL; C6orf108; dJ330M21.3应用: WB,IHC反应种属: Human
-
分类: 科研抗体货号: P10289别名: F52; MLP; MRP; MLP1; MACMARCKS应用: WB,IHC反应种属: Human, Mouse, Rat
-
分类: 科研抗体货号: P10269别名: GCE; NKH应用: IHC反应种属: Human, Mouse, Rat
-
分类: 科研抗体货号: P10288别名: SLMO2; C20orf45; dJ543J19.5应用: IHC反应种属: Human, Mouse, Rat
-
分类: 科研抗体货号: P10268别名: AG1; AGR1; ERP16; ERP18; ERP19; TLP19; hAG-1; PDIA16; hTLP19应用: IHC反应种属: Human, Mouse, Rat
-
分类: 科研抗体货号: P10287别名: CRP2; LMO5; SmLIM应用: WB,IHC反应种属: Human, Mouse, Rat
-
分类: 科研抗体货号: P10267别名: CIP; CINAP; AD-004; hCINAP; CGI-137应用: WB反应种属: Human, Mouse, Rat
-
分类: 科研抗体货号: P10286别名: BDR1; HLP2; VILIP-3应用: WB,IHC反应种属: Human, Mouse, Rat
-
分类: 科研抗体货号: P10266别名: PA; HPS9; PLDN; BLOS6; PALLID应用: WB,IHC反应种属: Human, Mouse, Rat

鄂公网安备42018502007531号
鄂公网安备42018502007531号

